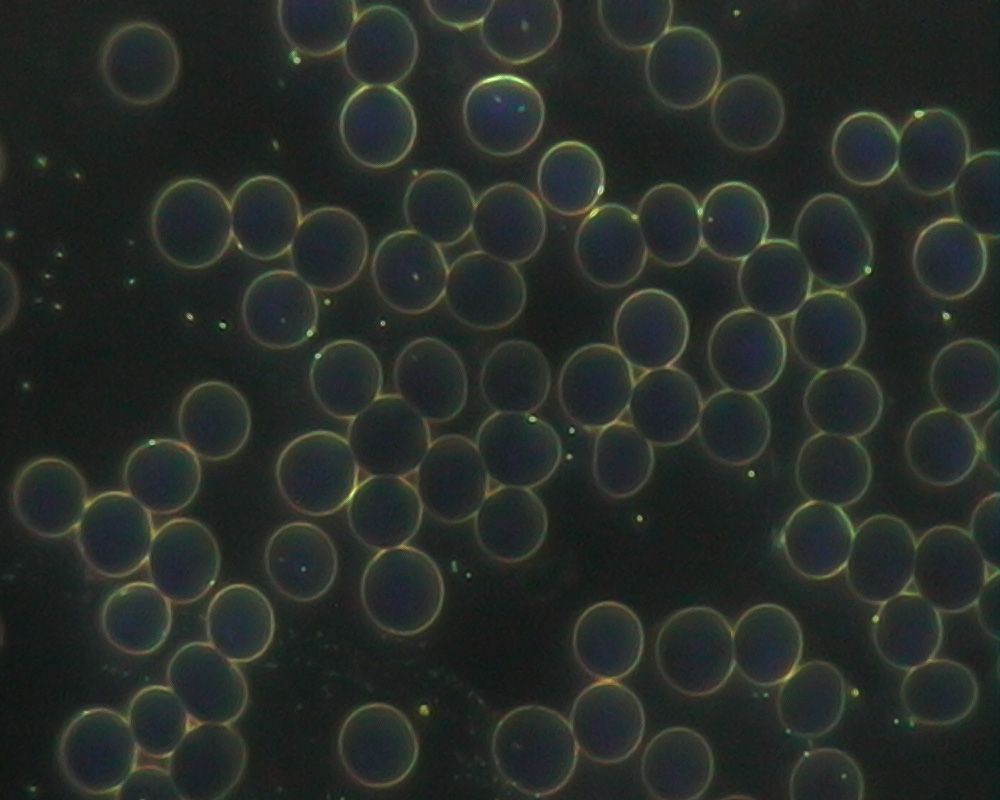
blood-after

There’s a big difference in natural and artificial alkaline drinking systems, and this is what makes AOX stand out from the usual alkaline ionizers. Traditional water ionizers use electricity to create a chemical change to produce artificial alkaline water – which results in generating acidic waste and emits damaging radiation. By contrast, there are numerous benefits in choosing a natural water dispenser such as AOX, which helps counteract the effects of an acidic diet and environmental pollutants. Boost your health today by fortifying your drinking water with AOX!
Take charge in maintaining your health and wellbeing with premium systems from AOX
AOX natural antioxidant alkaline filters alkalize your water through the generous infusion of hydrogen, oxygen and negatively charged ions. This gives your water millions of powerful antioxidants which is highly effective in removing free radicals (the leading causes for cancer, diabetes, hypertension, hypotension and gout). Antioxidants also work just like Vitamin C in that they strengthen your immune system and promote anti-aging, keeping you looking and feeling fresh and youthful.
Below are four reasons why our water dispensers have become a must have in many Singapore households:
AOX natural antioxidant alkaline filters reduce the water molecules into smaller clusters, allowing your body to be hydrated more efficiently than through drinking normal water. It also boosts your body’s absorption rate of nutrients and essential minerals.
AOX natural antioxidant alkaline filters alkalise your water, making it capable of restoring pH balance in your body and flushing acidic metabolites and toxins in the cellular level.
AOX natural antioxidant alkaline filters mineralize your water with health-sustaining minerals such as calcium, potassium, magnesium, sodium and silica to promote healthy cells, bones, joints, organs and skin. (Presence of minerals has been tested by HSA Singapore.)
AOX natural antioxidant alkaline filters remove dust, sand, rust and other forms of sediments in your drinking system. AOX removes harmful chemicals and cancer causing substances such as chlorine, THM, pesticides and carcinogens. It also eradicates odour, making the final product smell and taste great!
The AOX Promise
BEFORE
Drinking AOX
Blood cells are clustered and damaged by free radicals
AFTER
Drinking AOX
Blood cells are separated and restored

6 thoughts on “Why Buy AOX”